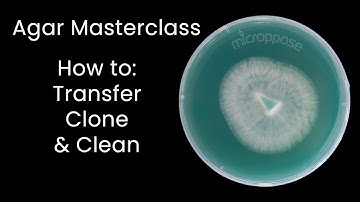
Master AGAR Techniques to Clone Cultures Like a Pro!

⬇ DOWNLOAD NOW
Kalau muncul iklan pop-up, tutup lalu klik tombol kembali
Download lagu How to Clone Mushrooms | Working With Agar secara gratis hanya untuk keperluan promosi. Dukung artis favorit kamu dengan membeli musik original di iTunes atau platform resmi lainnya.
 How to Clone Mushrooms | Mycology Skills! #howto #environment #lab
How to Clone Mushrooms | Mycology Skills! #howto #environment #lab
 Mushroom Cloning Basics
Mushroom Cloning Basics
 Mycology Lab 101: Agar Work, Cloning, Spores & Sterile Culture Technique for Mushroom Cultivation
Mycology Lab 101: Agar Work, Cloning, Spores & Sterile Culture Technique for Mushroom Cultivation
 How To CLONE MUSHROOMS Using Agar | Cowan's Fantastic Fungi
How To CLONE MUSHROOMS Using Agar | Cowan's Fantastic Fungi
 How To Clone A Mushroom Using Agar
How To Clone A Mushroom Using Agar
 How To Clone Mushrooms
How To Clone Mushrooms
Master AGAR Techniques to Clone Cultures Like a Pro!
Master AGAR Techniques to Clone Cultures Like a Pro!
 Save genetics for years #mycology #mushroom #agar
Save genetics for years #mycology #mushroom #agar